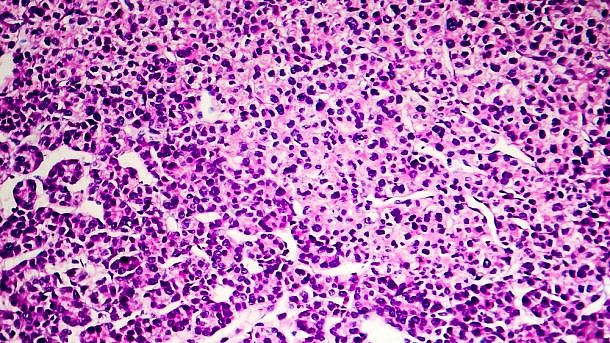

גרורות הן עדיין מכשול מכריע בדרך לטיפול בקרצינומת תאי כבד. עניין גדול נרשם לאחרונה בחקר האפקט האנטי-גידולי של תרכובות צמחי מרפא ובפרט של גרורות של קרצינומת תאי כבד. כטריטרפנואיד ספונין, ישנם דיווחים לאחרונה כי α-Hederin מדגים ציטוטוקסיות כנגד מגוון שורות של תאים סרטניים באמצעות השריית אפופטוזיס המקושר למיטוכונדריה או מוות תאי אוטופאגי. בכל אופן, מעט מאוד ידוע אודות האפקט המעכב של α-Hederin על גרורות של קרצינומת תאי כבד והמנגנון מאחורי אפקט זה.
במחקר שממצאיו תוארו בעיתון Pharmacological Research שילבו החוקרים כלי רשת מנבא מבוסס היטב ושיטות עיגון מולקולריות על מנת לנבא מטרות פוטנציאליות עבור α-Hederin, וכך לבסוף התרכזו החוקרים PTAFR, הקולטן לפקטור שפעול טסיות. שפעול של מסלול ה-PAF/PTAFR דווח כגורם התרום לתחילת וקידום התהליך הסרטני.
תוצאות המחקר הראו בפעם הראשונה כי ריכוז לא ציטוטוקסי של α-Hederin הביא לעיכוב של נדידת תאים של קרצינומת תאי כבד ופלישתם המתווכת על ידי פקטור שפעול טסיות, זאת בנוסף לגרורות לריאה בגוף חי. יתרה מכך, נמצא כי α-Hederin הביא לירידה בביטוי של מטאלופרוטאינאזות 2 המושרה על ידי פקטור שפעול טסיות וזאת דרך עיכוב השפעול של STAT3 בתאי קרצינומת כבד מעוררים.
ממצאים אלה מעידים על כך ש-α-Hederin מתפקד כמעכב פרוספקטיבי של PTAFR ובכך יכול להיות שמיש כמועמד למטרה טיפולית במקרים של קרצינומת תאי כבד.
מקור:
Cao L. et al. Pharmacological Research (2022).
https://doi.org/10.1016/j.phrs.2022.106180